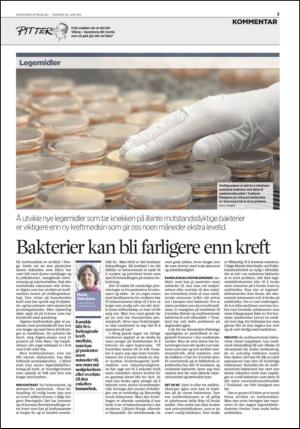
aftenbladet-20110630_000_00_00_003.pdf

Stavanger Aftenblad 2011-06-30
Stavanger Aftenblad 2011-06-30 är en utgåva av publikationen Stavanger Aftenblad. Utgåvan innehåller 36 sidor som du kan se nedan . Utgåvan har 1 bilagor som du kan href = "#pfc-supplements">se nedan. PDF filen av utgåvan har storleken 11,60 MB. Den föregående utgåvan av denna publikation är Stavanger Aftenblad 29.06.11. Nästa utgåva av denna publikation är Stavanger Aftenblad 01.07.11. Klicka på publikationens länk Stavanger Aftenblad se information om andra utgåvor.
Publikationen Stavanger Aftenblad är en tidning och publiceras av förlaget Stavanger Aftenblad. Den första och sista utgåvan av denna publikation i arkivet är Stavanger Aftenblad 10.11.04 respektive Stavanger Aftenblad 24.02.26.
Arkivet till Stavanger Aftenblad innehåller 9950 utgåvor som representerar 518919 sidor. Alla utgåvorna är indexerade i vårat sökbara arkiv.

 Engelska
Engelska Norska
Norska Svenska
Svenska